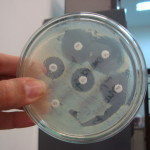

התגלה פרימט מאובן בגודל עכבר שחי לפני 55 מיליון שנה

הפרימטים הם סדרה במחלקת היונקים אשר כוללת למעלה מ-200 מיני קופים, קופיפים וקופי האדם. גם האדם שייך למשפחה זו. בשנת 2002 התגלה בסין שלד כמעט שלם אשר לקח עשר שנים לפיענוחו המלא. השלד הוא של יצור בעל גפיים רזות וזנב ארוך, גודלו כגודל עכבר והוא חי לפני כ-55 מיליון שנה, מה שהופך אותו להיות מאובן… המשך הקריאה